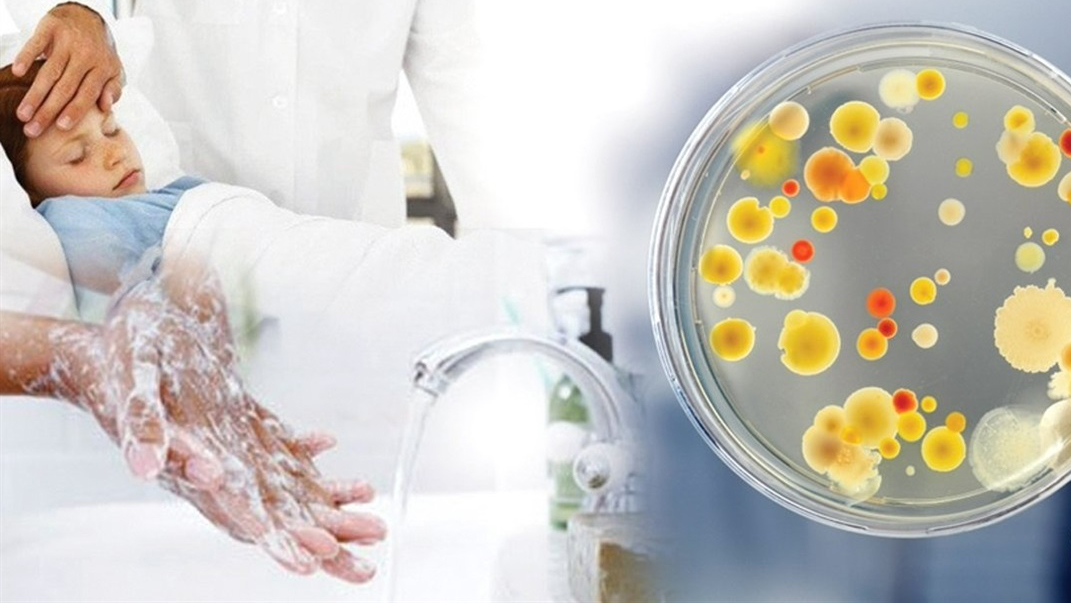
Інформує Лубенський підрозділ ДУ "«Полтавський обласний центр контролю та профілактики хвороб"

У зв’язку із проведенням робіт у мережах АТ «ПОЛТАВАОБЛЕНЕРГО» можливі тимчасові перерви в електропостачанні споживачів. Дата, орієнтовний час початку та закінчення перерви вказані у таблиці
Слава Україні! Розпочалась 923-тя доба широкомасштабної збройної агресії російської федерації проти України. Протягом минулої доби зафіксовано 197 бойових зіткнень. Найгарячіша ситуація була на Покровському напрямку, також противник був активним на Курахівському, Времівському та Куп'янському напрямках.
За уточненою інформацією, за вчора противник завдав по позиціях українських підрозділів та населених пунктах три удари, застосувавши 33 ракети, та 68 авіаударів, скинувши 77 КАБів. Крім цього, здійснив понад 3900 обстрілів, з них 139 - із реактивних систем залпового вогню. Агресор завдавав авіаударів у районах населених пунктів Глухів, Білопілля, Заруцьке Сумської області; Григорівка, Дружба, Дачне, Торецьк, Олександропіль, Мирноград, Селидове, Костянтинівка, Богатир Донецької області; Новодарівка, Мала Токмачка, Оріхів, Новоандріївка Запорізької області; Козацьке Херсонської області.
Вчора авіація та ракетні війська і артилерія Сил оборони завдали 12 ударів по районах зосередження особового складу та ОВТ противника. Крім цього, уразили артилерійську систему та дві понтонні переправи.
На Харківському напрямку відбулося п’ять боєзіткнень поблизу Вовчанська. На Куп’янському напрямку точилося 23 бої. Сили оборони відбивали штурмові дії противника неподалік Синьківки, Петропавлівки, Глушківки, Колісниківки, Стельмахівки та Берестового.
Українські захисники продовжують рішуче давати відсіч спробам противника просунутися в глибину нашої території, завдають йому ефективного вогневого ураження, виснажуючи по всій лінії фронту.
31 серпня Лубенська територіальна громада долучилася до Всеукраїнського забігу «Шаную воїнів, біжу за героїв України!». Забіг був присвячений Дню пам’яті захисників України, які загинули за суверенітет і територіальну цілісність нашої держави. Мета забігу – згадати загиблих та продемонструвати вдячність рідним полеглих воїнів. Ініціаторами забігу стали у 2018 році Олег Дурмасенко, Таїсія Братасюк, Дмитро Примаченко. За роки свого існування географія забігу розширилася від регіонів України до майже 40 країн світу.
Територіальний центр соціального обслуговування (надання соціальних послуг) Лубенської міської ради забезпечує соціальними послугами пенсіонерів та інвалідів міста. На даний час на обліку знаходиться більше 1900 осіб, з них 94 ветеранів війни та 20 інвалідів війни.
Зустрічаємо осінь, володарку щедротних урожаїв. У коморах збіжжя, надбане трудолюбивими українцями, а у нашій громаді – поповнення: на світ з’явилися хлопчики та дівчатка.
За інформацією Управління охорони здоров’я виконавчого комітету Лубенської міської з 24.02.2022 р. по 02.09.2024 р. в пологовому відділенні КП «Лубенська лікарня інтенсивного лікування» ЛМР народилася 771 дитина: 380 дівчаток і 391 хлопчик, в тому числі за 2024 рік народилося 157 дітей : 74 дівчинки і 83 хлопчики.
Нехай вам щастить, малеча! Зростайте у мирі і добрі та при гарному здоров’ї.
Лубенський районний відокремлений підрозділ Державної установи «Полтавський обласний центр контролю та профілактики хвороб Міністерства охорони здоров’я України» інформує щодо захворюваності на гострі респіраторні інфекції за 35-й тиждень 2024 року.
У зв’язку із проведенням робіт у мережах АТ «ПОЛТАВАОБЛЕНЕРГО» можливі тимчасові перерви в електропостачанні споживачів. Дата, орієнтовний час початку та закінчення перерви вказані у таблиці
Слава Україні! Розпочалась 922-га доба широкомасштабної збройної агресії російської федерації проти України. Ситуація на фронті залишається складною. Противник, використовуючи свою перевагу в живій силі та техніці, безупинно атакує наші позиції. Українські захисники стійко стримують натиск окупантів, завдають ворогу значних втрат. Загалом, протягом минулої доби зафіксовано 182 бойових зіткнення. За уточненою інформацією, вчора противник завдав по позиціях українських підрозділів та населених пунктах чотирьох ракетних ударів із застосуванням 19 ракет, а також 71 авіаудар, зокрема, скинув 91 КАБ. Крім цього, здійснив більш як 4500 обстрілів населених пунктів та позицій наших військ, з них 141 - із реактивних систем залпового вогню. Агресор завдавав авіаударів, зокрема в районах населених пунктів Білопілля, Велика Писарівка, Бунякіне, Ободи Сумської області; Петропавлівка, Куп’янськ-Вузловий Харківської області; Дачне, Дружба, Олександропіль, Вугледар, Велика Новосілка, Селідове Донецької області; Новоандріївка, П’ятихатки на Запоріжжі.
Вчора авіація та ракетні війська і артилерія Сил оборони завдали 15 ударів по районах зосередження особового складу і ОВТ противника та двох засобах ППО противника. На Харківському напрямку ворог продовжував наступальні (штурмові) дії, загалом відбулося сім бойових зіткнень. Бої точилися в районах населених пунктів Вовчанськ та Липці. На Куп’янському напрямку за добу відбулося 16 ворожих атак. Сили оборони відбивали штурмові дії противника біля Синьківки та Глушківки.Українські захисники продовжують рішуче давати відсіч спробам противника просунутися в глибину нашої території, завдають йому ефективного вогневого ураження, виснажуючи по всій лінії фронту.
Шановні школярі, студенти, вчителі, батьки! Прийміть найщиріші вітання з Днем знань!
Початок нового навчального року - час для кожного поставити перед собою нові завдання, цілі, до яких потрібно прагнути, наполегливо йти, не шкодуючи сил та власного потенціалу.
Бажаємо здобувачам освіти допитливості, енергії, нових відкриттів та звершень. Особливі вітання першокласникам. Для вас, юні школярі, відкриваються нові шляхи і можливості, нові знання, які ви будете отримувати разом з новими друзями. Нехай у вас ніколи не зникає інтерес до навчання, а кожен день приносить тільки задоволення і радість.
Шановні підприємці Лубенської громади!
Щиро вітаємо вас із професійним святом!
З великою вдячністю віддаємо вам шану за вашу наполегливу працю, високий професіоналізм та ініціативність, активну громадянську позицію та патріотизм. Саме завдяки вам економіка нашої громади встояла під час війни. Саме ви створюєте комфортні умови для мешканців нашої громади та її гостей і забезпечуєте надійний тил для наших захисників.
Бути публічною книгозбірнею означає досяжність та змогу отримати книгу будь-якому мешканцю громади. А що робити, коли здоров’я, відстань чи справи роблять для вас бібліотеку недосяжною? Що ж, тоді книга прийде до вас! Щойно Лубенська публічна бібліотека імені В. Малика отримала мобільний засіб для доставки книг – велорикшу! А до неї у чарівній скринці – популярні та розвиваючі ігри для юних читачів та новенький ноутбук. Усі ці вкрай потрібні надбання стали можливі завдяки проєкту «Мобільна бібліотека – територія читання і дозвілля», який книгозбірня виграла серед сотень інших, ініційованих Благодійним фондом «МХП- Громаді». До речі, явище мобільної бібліотеки виникло ще кілька століть тому. Вважається, що перша пересувна бібліотека з'явилася в Англії наприкінці 1850-х років. А вже в 70-х роках ХХ століття пересувні книгозбірні «Бібліотека на колесах» та «Мандрівний бібліотечний центр» виникли в США. В ті ж роки працювали мобільні бібліотеки і в нашому регіоні.